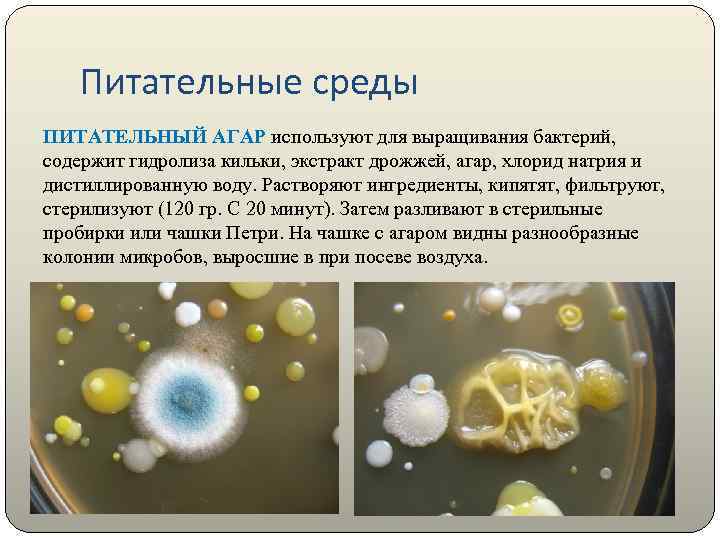
Питательные среды ПИТАТЕЛЬНЫЙ АГАР используют для выращивания бактерий, содержит гидролиза кильки, экстракт дрожжей, агар,

03. Методы исследования в микробиологии (презентация).ppt
- Количество слайдов: 36

Общая Микробиология.

Организация микробиологической лабораторной службы.

Правила работы в микробиологической лаборатории В микробиологической практике используют, главным образом, чистые культуры микроорганизмов, т. е. популяции микроорганизмов одного вида, часто являющихся потомством одной клетки. При исследованиях с не идентифицированными микроорганизмами, при их выделении из объектов окружающей среды и техногенных потоков, могут быть выделены патогенные и условно патогенные микроорганизмы.


По внешнему виду различают кокковые (шаровидные), палочковидные и спиралевидно-извитые формы бактерий Кокковые бактерии в зависимости от расположения отдельных клеток относительно друга разделяют на группы: 1)микрококки - имеют одиночное и беспорядочное расположение клеток; 2) диплококки - представляют сцепление двух кокков; 3) стрептококки - располагаются цепочками различной длины ; 4) тетракокки - отдельные кокки, сцепленные по четыре. 5) стафилококки -скопление кокков, напоминающие грозди винограда; 6) сарцины - выглядят в виде пакетов или тюков, по 8 -16 кокков в каждом.

1 4 2 5 3 6

Палочковидные (цилиндрические) формы бактерий могут быть короткие и длинные, толстые и тонкие, прямые и изогнутые, с наостренными, округленными или прямыми концами. Они бывают спорообразующими (бациллы) и неспорообразующими (бактерии). По взаимному расположению клеток относительно друга их делят па одиночные, диплобактерии и динлобациллы, стрептобактерии и стрептобациллы.

Палочковидные

Спиралевидно-извитые бактерии по длине, числу и размеру витков разделяют на: 1)вибрионы - короткие слегка изогнутые бактерии, имеющие вид запятой; 2)спириллы - более длинные бактерии с несколькими (56 крупными завитками); 3)спирохеты - тонкие длинные бактерии со многими мелкими завитками в виде штопора. 1 2 3

Питательные среды ПИТАТЕЛЬНЫЙ АГАР используют для выращивания бактерий, содержит гидролиза кильки, экстракт дрожжей, агар, хлорид натрия и дистиллированную воду. Растворяют ингредиенты, кипятят, фильтруют, стерилизуют (120 гр. С 20 минут). Затем разливают в стерильные пробирки или чашки Петри. На чашке с агаром видны разнообразные колонии микробов, выросшие в при посеве воздуха.



КРОВЯНОЙ АГАР питательная среда для выявления гемолитических свойств бактерий. К расплавленному остуженному (до 45 -50 гр С) питательному агару асептически добавляют 5 -10% дефибринированной крови, хорошо перемешивают и сразу же разливают в чашки Петри. Вокруг выросших колоний отчетливо видны прозрачные зоны гемолиза

ЖЕЛТОЧНО-СОЛЕВОЙ АГАР ЧИСТОВИЧА - селективная среда, предназначенная для культивирования стафилококков. Содержит питательный агар, желток куриного яйца, повышенные концентрации хлорида натрия (8 -10%), которые не препятствуют размножению стафилококков и обеспечивают элективность среды для данных микробов. Среда позволяет дифференцировать лецитиназопозитивные стафилококки, вокруг колоний которых образуются зоны помутнения с перламутровым оттенком.

СРЕДА ЭНДО предназначена для выделения энтеробактерий, обнаружения эшерихий. Состоит из питательного агара, 1% лактозы и индикатора – основного фуксина, обесцвеченного сульфитом натрия. Свежеприготовленная среда бесцветна или имеет бледно-розовую окраску. При росте лактозоположительных бактерий их колонии окрашиваются в темно-красный цвет с металлическим блеском; лактозоотрицательные кишечные палочки образуют бесцветные колонии

Фазы роста Рост периодической культуры бактерий, выращиваемых на жидкой питательной среде, подразделяют на несколько фаз: 1. лаг-фаза — период между посевом бактерий и началом размножения. Продолжительность лаг-фазы в среднем 4— 5 ч. Бактерии при этом увеличиваются в размерах и готовятся к делению; нарастает количество нуклеиновых кислот, белка и других компонентов. 2. фаза логарифмического роста является периодом интенсивного деления бактерий. Продолжительность ее около 5— 6 ч. При оптимальных условиях роста бактерии могут делиться каждые 20— 40 мин. 3. фаза стационарного роста, или максимальной концентрации бактерий; ( количество жизнеспособных клеток остается без изменений, составляя максимальный уровень (М-концентрация)). 4. фаза гибели бактерий (характеризуюется отмиранием бактерий в условиях истощения источников питательной среды и накопления в ней продуктов метаболизма бактерий)


Размножение бактерий в жидкой питательной среде Бактерии, засеянные в определенный, не изменяющийся объем питательной среды, размножаясь, потребляют питательные элементы, что приводит в дальнейшем к истощению питательной среды и прекращению роста бактерий. Культивирование бактерий в такой системе называют периодическим культивированием, а культуру — периодической. Если же условия культивирования поддерживаются путем непрерывной подачи свежей питательной среды и оттока такого же объема культуральной жидкости, то такое культивирование называется непрерывным, а культура — непрерывной. При выращивании бактерий на жидкой питательной среде наблюдается придонный, диффузный или поверхностный (в виде пленки) рост культуры.


Стерилизация. Стерилиза ция — полное освобождение какого-либо предмета от всех видов микроорганизмов, включая бактерии и их споры, грибы, вирионы, а также от прионного белка, находящихся на поверхностях, оборудовании, в пищевых продуктах и лекарствах. Тепловая стерилизация основана на чувствительности микробов к высокой температуре. При +60 о. С и наличии воды происходит денатурация белков, в том числе ферментов, вследствие чего вегетативные формы микробов погибают. Стерилизация сухим жаром происходит в сухожаровых шкафах, или печах Пастера. Обеззараживание материала в нем происходит при 160 -170°C в течение 60 -120 мин. Недостаток: высокую температуру выдерживают только некоторые стерилизуемые предметы(лабораторное стекло)



Паровая стерилизация Осуществляется подачей насыщенного водяного пара под давлением в паровых стерилизаторах (автоклавах). Стерилизуют перевязочный материал, белье, инструменты, питательные среды, растворы, инфекционный материал.

Режимы паровой стерилизации 132 °C — 2 атмосферы(2 кгс/см 2) — 20 минут — основной режим. Стерилизуют все изделия (стекло, металл, текстиль, КРОМЕ РЕЗИНОВЫХ). 120 °C — 1, 1 атмосфера(1, 1 кгс/см 2) — 45 минут — щадящий режим (стекло, металл, резиновые изделия, полимерные изделия — согласно паспорту, текстиль) 110 °C — 0, 5 атмосферы(0, 5 кгс/см 2) — 180 мин — особо щадящий режим (нестойкие препараты, питательные среды)

Дезинфекция - это обеззараживание объектов окружающей среды с помощью химических веществ, обладающих антимикробным действием. Цель дезинфекции – предупредить передачу возбудителей от инфицированного организма неинфицированному. Химическую дезинфекцию проводят с помощью различных дезинфицирующих веществ.

В микробиологический лаборатории используют: 1. хлорную известь (0, 1 – 10% раствор); 2. хлорамин (0. 5 -5% раствор), для дезинфекции рук 0, 25 – 0, 5% раствор, для дезинфекции предметов ухода за больными при кишечных и воздушнокапельных инфекциях 1 -3% раствор, при туберкулезе – 5% раствор; 3. фенол (карболовая кислота) в виде 3 – 5% раствора для дезинфекции помещений; 4. лизол (3 – 5% раствор); 5. биглюконат хлоргексидина (гибитан), для дезинфекции рук 0, 5% раствор, для дезинфекции помещений 0, 1% раствор; 6. дихлорид ртути (сулема) – иногда используют для дезинфекции предмете ухода за больными. Препарат высокотоксичен, всасывается через кожу.

Тепловая дезинфекция включает воздействие горячей водой и насыщенным паром: при 80°C – 10 мин; при 85°C – 3 мин; при 90°C – 1 мин. При этом режиме погибают все вегетативные формы бактерий и большинство вирусов. Ультрафиолетовое облучение происходят с помощью специальных бактерицидных ламп (настенных, потолочных, передвижных) для обеззараживания воздуха, различных поверхностей.

Утилизация отходов. отходы подразделяются на классы в зависимости от степени их опасности: Класс А – Неопасные отходы; Класс Б – Опасные отходы; Класс В – Чрезвычайно опасные отходы; Класс Г – Близкие по составу к промышленным;




Вирусология — раздел микробиологии, изучающий вирусы (от латинского слова virus — яд). Вирусы обладают уникальными свойствами, которые позволяют выделить их из общей массы микроорганизмов: Наличие только одного из двух видов нуклеиновых кислот. Отсутствие собственной белок-синтезируемых систем. Они представляют собой генетических паразитов. Вирусы не растут, а только репродуцируются (размножаются). Впервые существование вируса (как нового типа возбудителя болезней) доказал в 1892 году русский учёный Д. И. Ивановский.

Лабораторная диагностика вирусных инфекций Для лабораторной диагностики вирусных инфекций используются различные методы. Вирусологическое исследование (световая микроскопия) позволяет обнаружить характерные вирусные включения, а электронная микроскопия - сами вирионы, и по особенностям их строения диагностировать соответствующую инфекцию (например, ротавирусную). Вирусологическое исследование направлено на выделение вируса и его идентификацию. Для выделения вирусов используют заражение лабораторных животных, куриных эмбрионов или культуры тканей.

Первичную идентификацию выделенного вируса до уровня семейства можно провести с помощью: - определения типа нуклеиновой кислоты (проба с бромдезоксиуридоном), - особенностей ее строения (электронная микроскопия), - размером вириона (фильтрование через мембранные фильтры с порами диаметром 50 и 100 нм), - наличия суперкапсидной оболочки (проба с эфиром), - гемагглютининов (реакция гемагглютинации), - типа симметрии нуклеокапсида (электронная микроскопия).

Вирусологическое исследование q. Вирусологическое исследование - это "золотой стандарт" вирусологии и должно проводится в специализированной вирусологической лаборатории. В настоящее время оно используется практически только в условиях возникновения эпидемической вспышки того или иного вирусного инфекционного заболевания. Для диагностики вирусных инфекций широкое применение нашли методы иммунодиагностики (серодиагностики и иммуноиндикации). Они реализуются в самых разнообразных реакциях иммунитета: qрадиоизотопный иммунный анализ (РИА), qиммуноферментный анализ (ИФА), qреакция иммунофлюоресценции (РИФ), qреакция связывания комплемента (РСК), qреакция пассивной гемагглютинации (РПГА), qреакции торможения гемагглютинации (РТГА) и другие.
03. Методы исследования в микробиологии (презентация).ppt